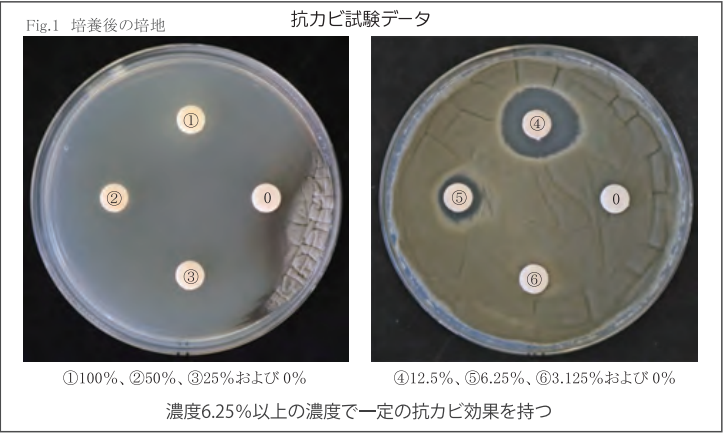

トイレの広さに合わせて選べる“1か月無料デモ”を全国で実施
株式会社アメニティのプレスリリース

株式会社アメニティ(本社:横浜市、代表取締役:山戸伸孝)は、新商品となる紙製消臭剤容器 「パピルス」 の発売を記念し、フレグランス消臭剤 「エフグラス」シリーズのキャンペーン を実施いたします。
本キャンペーンでは植物精油の力を活かした消臭と香りの演出を、トイレ空間の広さや用途に合わせて体感できる 「1か月無料デモプラン」 を用意しました。キャンペーン期間は 2026年1月1日〜4月30日 まで、全国のアメニティネットワークを通じて展開します。
トイレの広さに合わせて選べる2つのプラン
プランA:小規模スペース・個室向け
パピルスは、ファンを使わない自然拡散方式を採用した紙製消臭剤容器です。
電池や電源を必要とせず、狭い個室でも消臭剤の効果をしっかり発揮できる設計となっています。

プランB:広いスペース・強力消臭向け
ボンボアはシロッコファンによって消臭剤を拡散し、広い空間でも消臭・芳香成分を行き渡らせる送風機です。
商業施設やバックヤードなど、広いスペースに適しています。

キャンペーン内容
今なら「1か月お試し無料」
(機器レンタル代・消臭剤代を含みます)
キャンペーン期間
2026年1月1日〜4月30日
フレグランス消臭剤「エフグラス」シリーズ
エフグラスは植物精油を使用したアロマ系消臭剤で、以下の香りをラインナップしています。
ユーカリ(おすすめ):消臭効果が高く、強いニオイ対策に最適
ウッディ:森林浴のような落ち着いた空間を演出
メントール:清涼感のあるストロングミント
リラックス:ラベンダー基調の穏やかな香り
ビタミン:柑橘系をイメージしたフレッシュな香り
科学的データによる裏付け
第三者機関による試験では、ユーカリを使用したエフグラスにおいてアンモニア濃度が60分後に98%減少する結果が確認されています。
また、抗カビ効果確認試験では、6.25%以上の濃度で抗カビ効果が認められました。

問い合わせ先
|
会社名 |
株式会社アメニティ |
|
所在地 |
〒221-0863 横浜市神奈川区羽沢町685 |
|
事業内容 |
トイレメンテナンス、消臭剤開発、設備機器レンタル、FC事業ほか |
|
URL |
|
|
TEL |
045-371-7676 |
|
|
amenity@do-amenity.co.jp |

